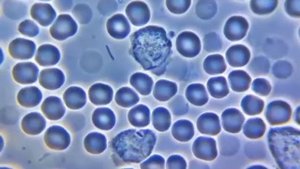
амебоидное движение

0:22
0:22
2022-12-28 16:26

 3:18
3:18

 3:18
3:18
2024-12-01 01:17

 14:42
14:42

 14:42
14:42
2023-12-06 20:06

 0:16
0:16

 0:16
0:16
2024-10-07 03:35

 0:22
0:22

 0:22
0:22
2023-11-16 16:12

 5:23
5:23

 5:23
5:23
2024-11-15 18:02

 0:06
0:06
0:06
0:06
2024-01-02 23:10

 3:04
3:04

 3:04
3:04
2024-04-20 05:30

 0:34
0:34

 0:34
0:34
2023-11-18 11:59

 1:07
1:07

 1:07
1:07
2023-12-22 15:14

 16:17
16:17

 16:17
16:17
2025-09-17 18:32

 8:59
8:59

 8:59
8:59
2023-09-14 21:07

 1:11
1:11

 1:11
1:11
2023-09-16 11:48

 14:19
14:19

 14:19
14:19
2023-09-19 21:45

 9:40
9:40

 9:40
9:40
2023-08-01 16:25

 0:17
0:17

 0:17
0:17
2022-12-08 02:15

 1:59
1:59

 1:59
1:59
2023-09-13 19:31

 0:15
0:15
![Сергей Сухачёв - Розовый туман (Премьера клипа 2025)]() 3:13
3:13
![Жасурбек Мирзажонов - Суймаганга суйкалдим (Премьера клипа 2025)]() 5:45
5:45
![Бьянка - Бренд (Премьера клипа 2025)]() 2:29
2:29
![MEDNA - Алё (Премьера клипа 2025)]() 2:28
2:28
![5sta Family - Антидот (Премьера клипа 2025)]() 3:33
3:33
![Хабибулло Хамроз - Хуп деб куёринг (Премьера клипа 2025)]() 4:04
4:04
![Рустам Нахушев, Зульфия Чотчаева - Каюсь (Премьера клипа 2025)]() 3:20
3:20
![Зара - Танго о двух влюбленных кораблях (Премьера клипа 2025)]() 3:10
3:10
![Tural Everest - Ночной город (Премьера клипа 2025)]() 3:00
3:00
![Gulinur - Nishatar (Official Video 2025)]() 3:40
3:40
![Алмас Багратиони - Сила веры (Премьера клипа 2025)]() 3:18
3:18
![Сергей Завьялов - В дороге (Премьера клипа 2025)]() 3:14
3:14
![SERYABKINA, Брутто - Светофоры (Премьера клипа 2025)]() 3:49
3:49
![Мужик из СИБИРИ (Александр Конев) - Не прощу (Премьера клипа 2025)]() 2:39
2:39
![Джатдай - Забери печаль (Премьера клипа 2025)]() 2:29
2:29
![Светлана Ларионова - Осень отстой (Премьера клипа 2025)]() 3:30
3:30
![Selena Gomez - In The Dark (Official Video 2025)]() 3:04
3:04
![Сергей Одинцов - Девочка любимая (Премьера клипа 2025)]() 3:56
3:56
![Дана Лахова - Одинокая луна (Премьера клипа 2025)]() 2:15
2:15
![KhaliF - Где бы не был я (Премьера клипа 2025)]() 2:53
2:53
![Только ты | All of You (2025)]() 1:38:22
1:38:22
![Плохой Cанта 2 | Bad Santa 2 (2016) (Гоблин)]() 1:28:32
1:28:32
![Супруги Роуз | The Roses (2025)]() 1:45:29
1:45:29
![Элис, дорогая | Alice, Darling (2022)]() 1:29:30
1:29:30
![Государственный гимн | Americana (2025)]() 1:47:31
1:47:31
![Обитель | The Home (2025)]() 1:34:43
1:34:43
![Терминатор 2: Судный день | Terminator 2: Judgment Day (1991) (Гоблин)]() 2:36:13
2:36:13
![Храброе сердце | Braveheart (1995)]() 2:57:46
2:57:46
![Стив | Steve (2025)]() 1:33:34
1:33:34
![Плюшевый пузырь | The Beanie Bubble (2023)]() 1:50:15
1:50:15
![Сумерки | Twilight (2008)]() 2:01:55
2:01:55
![Диспетчер | Relay (2025)]() 1:51:56
1:51:56
![Эффект бабочки | The Butterfly Effect (2003)]() 1:53:35
1:53:35
![Дикари | The Savages (2007)]() 1:54:19
1:54:19
![Положитесь на Пита | Lean on Pete (2017)]() 2:02:04
2:02:04
![Баллада о маленьком игроке | Ballad of a Small Player (2025)]() 1:42:60
1:42:60
![Мужчина у меня в подвале | The Man in My Basement (2025)]() 1:54:48
1:54:48
![Французский любовник | French Lover (2025)]() 2:02:20
2:02:20
![Сверху вниз | Highest 2 Lowest (2025)]() 2:13:21
2:13:21
![Богомол | Samagwi (2025)]() 1:53:29
1:53:29
![Минифорс. Сила динозавров]() 12:51
12:51
![Сборники «Зебра в клеточку»]() 45:30
45:30
![Команда Дино. Исследователи Сезон 2]() 13:26
13:26
![Ну, погоди! Каникулы]() 7:09
7:09
![МиниФорс Сезон 1]() 13:12
13:12
![Мультфильмы военных лет | Специальный проект к 80-летию Победы]() 7:20
7:20
![Чуч-Мяуч]() 7:04
7:04
![Хвостатые песенки]() 7:00
7:00
![Супер Дино]() 12:41
12:41
![Игрушечный полицейский Сезон 1]() 7:19
7:19
![Корги по имени Моко. Защитники планеты]() 4:33
4:33
![МиниФорс]() 0:00
0:00
![Чемпионы]() 7:35
7:35
![Сборники «Ну, погоди!»]() 1:10:01
1:10:01
![Забавные медвежата]() 13:00
13:00
![Папа Супергерой Сезон 1]() 4:28
4:28
![Умка]() 7:11
7:11
![Приключения Тайо]() 12:50
12:50
![Сборники «Умка»]() 1:20:52
1:20:52
![Новогодние мультики – Союзмультфильм]() 7:04
7:04

 0:15
0:15Скачать видео
| 296x240 | ||
| 440x360 | ||
| 592x480 |
 3:13
3:13
2025-10-24 12:18
 5:45
5:45
2025-10-27 13:06
 2:29
2:29
2025-10-25 12:48
 2:28
2:28
2025-10-21 09:22
 3:33
3:33
2025-10-22 13:57
 4:04
4:04
2025-10-28 13:40
 3:20
3:20
2025-10-30 10:39
 3:10
3:10
2025-10-27 10:52
 3:00
3:00
2025-10-28 11:50
 3:40
3:40
2025-10-31 13:38
 3:18
3:18
2025-10-24 12:09
 3:14
3:14
2025-10-29 10:28
 3:49
3:49
2025-10-25 12:52
 2:39
2:39
2025-10-30 11:00
 2:29
2:29
2025-10-24 11:25
 3:30
3:30
2025-10-24 11:42
 3:04
3:04
2025-10-24 11:30
 3:56
3:56
2025-10-28 11:02
 2:15
2:15
2025-10-22 14:16
 2:53
2:53
2025-10-28 12:16
0/0
 1:38:22
1:38:22
2025-10-01 12:16
 1:28:32
1:28:32
2025-10-07 09:27
 1:45:29
1:45:29
2025-10-23 18:26
 1:29:30
1:29:30
2025-09-11 08:20
 1:47:31
1:47:31
2025-09-17 22:22
 1:34:43
1:34:43
2025-09-09 12:49
 2:36:13
2:36:13
2025-10-07 09:27
 2:57:46
2:57:46
2025-08-31 01:03
 1:33:34
1:33:34
2025-10-08 12:27
 1:50:15
1:50:15
2025-08-27 18:32
 2:01:55
2:01:55
2025-08-28 15:32
 1:51:56
1:51:56
2025-09-24 11:35
 1:53:35
1:53:35
2025-09-11 08:20
 1:54:19
1:54:19
2025-08-27 18:01
 2:02:04
2:02:04
2025-08-27 17:17
 1:42:60
1:42:60
2025-10-31 10:53
 1:54:48
1:54:48
2025-10-01 15:17
 2:02:20
2:02:20
2025-10-01 12:06
 2:13:21
2:13:21
2025-09-09 12:49
 1:53:29
1:53:29
2025-10-01 12:06
0/0
 12:51
12:51
2024-11-27 16:39
 45:30
45:30
2025-09-17 18:49
2021-09-22 22:54
 7:09
7:09
2025-08-19 17:20
2021-09-23 00:15
 7:20
7:20
2025-05-03 12:34
 7:04
7:04
2022-03-29 15:20
 7:00
7:00
2025-06-01 11:15
 12:41
12:41
2024-11-28 12:54
2021-09-22 21:03
 4:33
4:33
2024-12-17 16:56
 0:00
0:00
2025-11-02 09:31
 7:35
7:35
2025-11-01 09:00
 1:10:01
1:10:01
2025-07-25 20:16
 13:00
13:00
2024-12-02 13:15
2021-09-22 21:52
 7:11
7:11
2025-01-13 11:05
 12:50
12:50
2024-12-17 13:25
 1:20:52
1:20:52
2025-09-19 17:54
 7:04
7:04
2023-07-25 00:09
0/0

